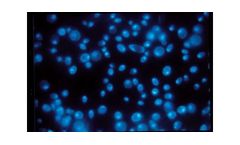
Cytiva Whatman - Cyclopore PC Polycarbonate Black Membrane Filter

- Home
- Equipment
Refine by
Cytiva Whatman Environmental Equipment & Supplies
46 equipment items found
Manufactured by:Cytiva based inMarlborough, MASSACHUSETTS (USA)
ReZist in-line filters are lightweight air venting units suitable for protective vents, in-line filtration, and isolation applications when working with chemically harsh ...
Manufactured by:Cytiva based inMarlborough, MASSACHUSETTS (USA)
Cytiva’s Whatman parchment weigh boats are designed so users can collect, transfer, and drop both sample and weighing boat into the acid solution during a Kjeldahl analysis without influencing analytical ...
Manufactured by:Cytiva based inMarlborough, MASSACHUSETTS (USA)
Cytiva’s clear Whatman polycarbonate membrane filters are made from a pure polymeric film that provides exceptional chemical cleanliness during microfiltration, as well as high visibility under the ...
Manufactured by:Cytiva based inMarlborough, MASSACHUSETTS (USA)
Whatman 3-Piece Filter Funnels from Cytiva are ideal for quick and easy filtration using high-efficiency glass microfiber ...
Manufactured by:Cytiva based inMarlborough, MASSACHUSETTS (USA)
Cytiva’s Whatman PM2.5 PTFE membrane filters are designed for PM 2.5 ambient air monitoring. These high-purity, thin filters are sequentially numbered and come with chemically resistant polypropylene support ...
Manufactured by:Cytiva based inMarlborough, MASSACHUSETTS (USA)
Cytiva’s Polydisc GW (Ground Water) is an in-line filter specifically designed for preparation of ground water samples for dissolved heavy metal ...
Manufactured by:Cytiva based inMarlborough, MASSACHUSETTS (USA)
Polydisc SPF disc filters from Cytiva contain a glass microfiber (GMF) and polyethersulfone (PES) stack designed to purify serum and other hard-to-filter ...
Manufactured by:Cytiva based inMarlborough, MASSACHUSETTS (USA)
Cytiva’s Whatman Grade 113V creped filter paper, for use with a conical filter funnel, offers fast filtration and high loading capacity for analysis involving coarse particles or gelatinous ...
Manufactured by:Cytiva based inMarlborough, MASSACHUSETTS (USA)
Whatman Grade 114V smooth filter paper from Cytiva is wet-strengthened for high mechanical stability. Grade 114V fluted filters are suitable for recovery of large particles and gelatinous ...
Manufactured by:Cytiva based inMarlborough, MASSACHUSETTS (USA)
Whatman Grade 1V lab filter paper from Cytiva Healthcare’s Life Sciences business is a widely used pre-folded filter for many general filtration ...
Manufactured by:Cytiva based inMarlborough, MASSACHUSETTS (USA)
Cytiva’s Whatman Grade 4V filter paper is well suited for qualitative analysis or general filtration of coarse particles. The fluted filter design increases filtration speed, flow rate, and loading ...
Manufactured by:Cytiva based inMarlborough, MASSACHUSETTS (USA)
Cytiva’s Whatman Grade 5V fine particle filter retains particles as small as 2.5 µm for qualitative analysis. This cellulose filter paper is fluted for ...
Manufactured by:Cytiva based inMarlborough, MASSACHUSETTS (USA)
Aqueous IFD from Cytiva is a polypropylene housed in-line filter/degasser (IFD) with nylon membrane. It connects to an HPLC line and simultaneously filters and degasses during HPLC mobile phase ...
Manufactured by:Cytiva based inMarlborough, MASSACHUSETTS (USA)
Whatman Polydisc AS (Aqueous Solution) in-line filters from Cytiva feature high-throughput PES membranes with a glass microfiber prefilter. Polydisc comes presterilized in medical-grade blister ...
Manufactured by:Cytiva based inMarlborough, MASSACHUSETTS (USA)
Whatman Grade GF 10 glass microfiber filters from Cytiva Healthcare’s Life Sciences business are made from borosilicate glass and strengthened with an organic binder to provide high mechanical ...
Manufactured by:Cytiva based inMarlborough, MASSACHUSETTS (USA)
Whatman Grade GF 6 glass microfiber filters from Cytiva Healthcare’s Life Sciences business are suitable for water and wastewater analysis, with extremely fine particle retention and added ...
Manufactured by:Cytiva based inMarlborough, MASSACHUSETTS (USA)
Whatman Grade GF 9 glass microfiber filters from Cytiva Healthcare’s Life Sciences business are strengthened with an inorganic binder for environmental analysis of coarse, heavy ...
Manufactured by:Cytiva based inMarlborough, MASSACHUSETTS (USA)
Cytiva’s Whatman EPM 2000 air filters are used in high-volume PM-10 sampling equipment. Manufactured from 100% pure borosilicate glass, they enable detailed chemical analysis of trace pollutants with minimal ...
Manufactured by:Cytiva based inMarlborough, MASSACHUSETTS (USA)
GE’s Whatman TCLP test filters are acid-treated with low metal content. They support TCLP testing by providing accurate information about TCLP limits to ensure the best possible disposal plan can be put into ...
Manufactured by:Cytiva based inMarlborough, MASSACHUSETTS (USA)
Cytiva’s Whatman brand Cyclopore black membrane filter is a polycarbonate track etch membrane (PCTE membrane) that provides a contrast background for epifluorescence and other microscopy ...